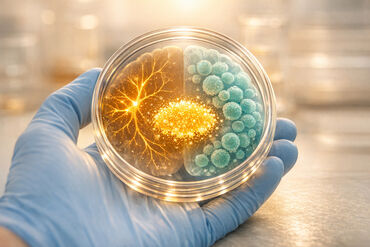
69a9d08612de151ab02776a3 1772740834893

The Evolution of Stem Cells: From Cord Blood to iPSC Technology
Stem cells have transformed medicine, offering new ways to treat diseases and repair tissues. Since the first cord blood transplant in 1988, advancements like induced pluripotent stem cells (iPSCs) have expanded possibilities from treating blood disorders to personalized therapies for conditions like diabetes and Parkinson’s. Today, the FDA approves stem cell treatments for over 80 conditions, with ongoing research promising even greater potential.
Key highlights:
- Cord blood stem cells: Used in over 40,000 transplants globally; effective for blood and immune system disorders.
- Cord tissue and placenta: Provide mesenchymal stem cells (MSCs) for structural tissue repair and inflammation reduction.
- Exosomes: Emerging as a cell-free therapy option for healing and regeneration.
- iPSCs: Adult cells reprogrammed to act like embryonic stem cells, offering unmatched versatility for disease modeling and personalized medicine.
Stem cell banking ensures families can access these therapies in the future. Americord offers plans for storing cord blood, tissue, and exosomes, preserving neonatal cells with fewer mutations for potential iPSC applications. With advancements in regenerative medicine, stem cell preservation bridges today’s treatments with tomorrow’s breakthroughs.
Cord Blood Stem Cells: Where It All Began
[Image of umbilical cord blood collection process]
The story of cord blood stem cells starts with a groundbreaking discovery that turned a once-discarded byproduct of childbirth into a life-saving medical resource. Before the late 1980s, umbilical cords were routinely thrown away after delivery. That changed when researchers identified hematopoietic stem cells (HSCs) in cord blood - cells capable of regenerating the entire blood and immune system. This revelation transformed cord blood into a vital tool for modern medicine.
Cord blood offered some distinct advantages over bone marrow. It was immediately available and came with a lower risk of acute graft-versus-host disease (GVHD). Unlike bone marrow transplants, which require invasive procedures and nearly perfect HLA matching and stem cell transplants, cord blood is collected non-invasively after birth and can work with partial mismatches. This made it a game-changer for patients who couldn’t find suitable bone marrow donors - a process that often takes weeks and has low success rates.
The First Cord Blood Transplant and Key Milestones
In October 1988, a major milestone was achieved when Dr. Eliane Gluckman performed the first successful cord blood transplant at Hôpital Saint-Louis in Paris. The recipient was Matthew Farrow, a five-year-old boy with Fanconi anemia, a genetic disorder that causes bone marrow failure. His newborn sister’s cord blood, collected in North Carolina and cryopreserved by Dr. Hal Broxmeyer in New York, was flown to Paris for the procedure.
Matthew’s immune system began functioning just 19 days after the transplant. Decades later, he remains healthy, proving that cord blood stem cells can provide long-term benefits. This success paved the way for a new treatment option for patients without bone marrow donors.
"It is remarkable that a routinely discarded substance can save lives." - Joanne Kurtzberg, M.D., President of the Cord Blood Association
Building on this breakthrough, Dr. Joanne Kurtzberg and her team at Duke University performed the first unrelated donor cord blood transplant on a four-year-old boy with T-cell leukemia. This demonstrated that publicly banked cord blood could save patients without family matches. By 1992, Dr. Pablo Rubinstein established the first public cord blood bank at the New York Blood Center, setting a global standard for donation and storage.
Since then, over 40,000 cord blood transplants have been performed worldwide, treating conditions like blood disorders, metabolic diseases, and cancers. Between 1988 and 2008, 233 clinical trials focused on cord blood. That number surged to 835 trials in the following decade, exploring its potential in treating neurological conditions such as cerebral palsy and autism.
These breakthroughs marked the shift from life-saving transplants to cutting-edge regenerative medicine.
Why Cord Blood Banking Matters
Cord blood banking offers families a form of biological insurance for future health challenges. Banked cord blood provides instant access to stem cells if needed, bypassing the lengthy search for unrelated donors and reducing the risk of acute GVHD. For siblings, there’s a 40% to 60% chance of a partial match, making privately stored cord blood especially valuable for families with multiple children.
| Feature | Cord Blood Stem Cells | Bone Marrow Stem Cells |
|---|---|---|
| Collection | Non-invasive; collected after birth | Invasive; requires surgical procedure |
| Availability | Immediate (if banked) | Weeks to months to find/harvest |
| HLA Matching | More flexible; tolerates partial mismatches | Requires near-perfect matching |
| GVHD Risk | Lower risk of acute graft-versus-host disease | Higher risk of graft-versus-host disease |
| Cell Potency | Highly proliferative/immature cells | More mature cells |
These early achievements laid the groundwork for advancements in stem cell therapies and preservation. Today, approximately 800,000 cord blood units are stored in public banks worldwide, alongside over 5 million units in private banks. With projections indicating that 1 in 3 people may eventually need regenerative therapies, cord blood banking is a forward-thinking way to prepare for medical challenges ahead.
Cord Tissue and Placental Stem Cells: Expanding Treatment Options
The success of cord blood banking has sparked growing interest in other birth tissues, particularly the umbilical cord and placenta. These tissues hold mesenchymal stem cells (MSCs), which can regenerate structural tissues such as bone, cartilage, muscle, and skin. Unlike hematopoietic stem cells (HSCs) from cord blood that target blood disorders, MSCs from cord tissue and placenta expand the possibilities for stem cell therapies.
What sets these cells apart is their versatility. MSCs from Wharton's Jelly in the umbilical cord focus on structural tissue repair, while the placenta contains both MSCs and amniotic epithelial cells (hAECs), which are especially effective in wound healing and reducing inflammation. Research also shows that placental MSCs can enhance HSC function, improving outcomes in co-transplantation by speeding up engraftment and lowering the risk of graft-versus-host disease.
Mesenchymal Stem Cells from Cord Tissue
Cord tissue MSCs are under investigation in over 300 clinical trials, targeting conditions that go beyond what cord blood can treat. These include neurological disorders such as autism, cerebral palsy, and Parkinson's disease, as well as orthopedic issues like arthritis and spinal cord injuries. While these therapies are still experimental and not yet FDA-approved, the early findings suggest a promising future.
Storing cord tissue alongside cord blood provides families with access to both HSCs and MSCs, offering numerous cord blood banking benefits. This dual approach opens the door to diverse treatment options, particularly as researchers explore how placental MSCs can help expand cord blood units for adult patients requiring higher cell doses. These advancements hint at groundbreaking possibilities in tissue preservation and regenerative medicine.
Placental Tissue 2.0™ and CryoMaxx™ Processing
Americord’s CryoMaxx™ processing introduces a new way to preserve placental and cord tissue. Instead of isolating cells before freezing, CryoMaxx™ preserves the tissue as a membrane, keeping its natural structure of growth factors and cytokines intact. This method helps placental tissue retain over 65% of the body’s essential proteins.
The Placental Tissue 2.0™ approach focuses on isolating the amnion layer, which contains amniotic epithelial cells and MSCs. This method allows for tissue storage in multiple vials, enabling treatments for various family members or future medical needs. The thin amnion layer is particularly useful for repairing burns, ulcers, and ocular injuries, while the thicker cord tissue works well as a surgical wrap. By preserving tissues in this way, a single birth can provide a wide range of therapeutic options for the baby, siblings, parents, or even grandparents. These advancements ensure that preserved tissues remain highly functional, offering new possibilities as medical science continues to evolve.
Exosomes: The Next Generation of Stem Cell Preservation
Exosomes present a cell-free alternative to traditional stem cell therapies. These tiny vesicles, ranging from 30 to 150 nanometers, transport proteins, lipids, RNA, and DNA to aid in healing. Unlike stem cell treatments that rely on live cells engrafting into the body, exosomes deliver therapeutic benefits without the significant risks of immune rejection or logistical challenges.
The scientific interest in exosomes is growing rapidly. As of October 2025, more than 40,000 publications on PubMed mention exosomes, and over 100 clinical trials are exploring their potential for treating conditions like pancreatic cancer and neurodegenerative disorders. Their appeal lies in their low immunogenicity and the ability to standardize their production, storage, and distribution - something that’s harder to achieve with living cells.
What Exosomes Are and How They Work
Exosomes are derived from the endosomal pathway inside cells and are released to facilitate communication between nearby or distant cells. They carry a variety of signaling molecules that can regulate immune responses, assist in wound healing, and promote cell development. This natural communication system makes them a promising tool for regenerative therapies that don’t require transplanting actual cells.
"Exosomes bypass several limitations associated with live-cell therapies: They exhibit lower immunogenicity, do not require engraftment to exert biological effects, and can be produced, stored, and distributed in a more standardized and scalable manner." - Dayana Ivanova, Marketing and Business Administration, REPROCELL
Unlike stem cells, exosomes cannot be expanded in culture. Instead, their preservation involves isolating and concentrating these naturally occurring vesicles to retain their therapeutic properties.
Americord's Exosome Banking Services
Americord is the first and only private cord blood bank in the U.S. offering exosome banking and biobanking services for both newborns and mothers. Using its proprietary CryoMaxx™ process, Americord isolates exosomes from newborn cord blood plasma as well as maternal biological materials collected during and after pregnancy.
The process is completely non-invasive and painless. Once isolated, the exosomes are cryopreserved at -196°C in nitrogen-cooled tanks at Americord's advanced facility in Somerset, NJ. While no FDA-approved exosome treatments currently exist, banking these materials provides families with the opportunity to access future clinical trials and therapies. By including exosome banking in its Maximum Family Plan, which builds upon the foundations of the Essential Family Plan, Americord gives families a head start in preparing for future advancements in regenerative medicine.
"By expanding our exosome banking services to encompass mothers, we aim to harness the full potential of regenerative medicine and empower families with enhanced medical options." - Martin Smithmyer, CEO and Founder, Americord
This forward-thinking approach to exosome banking highlights Americord's dedication to advancing regenerative medicine and positions families to benefit from the next wave of breakthroughs, including developments in iPSC technology.
Induced Pluripotent Stem Cells (iPSCs): A New Era in Medicine
While cord blood and exosomes occur naturally, induced pluripotent stem cells (iPSCs) are something entirely different. These are adult cells reprogrammed to behave like embryonic stem cells, making it possible to create virtually any cell type from adult tissue.
Here’s the game-changer: iPSCs are pluripotent, meaning they can develop into any cell type - whether it’s neurons, heart muscle, or liver tissue. On the other hand, cord blood stem cells are multipotent, which limits them to specific lineages like blood or immune cells. This ability to differentiate into a broader range of cells makes iPSCs a powerful tool for tackling conditions outside the scope of cord blood therapies. It all started with the realization that reprogramming adult cells could restore their full developmental potential.
Yamanaka's 2006 Discovery of iPSCs
In 2006, Shinya Yamanaka made a groundbreaking discovery: by introducing four specific genes - Oct4, Sox2, Klf4, and c-Myc - adult cells could be reprogrammed into a pluripotent state. By the following year, human iPSCs had been successfully created.
These "Yamanaka factors" essentially reset adult cells, turning them into stem cells capable of unlimited division and differentiation. The process takes about 3–4 weeks, but only a tiny fraction of cells (0.01%–0.1%) make the transformation. The resulting iPSCs are genetically identical to the patient, which eliminates the risk of immune rejection.
"The discovery made it crystal clear that cell identity is much more malleable than previously thought, and provided an invaluable tool for disease-oriented and translational researchers."
– Eirini P. Papapetrou, MD, PhD, Icahn School of Medicine at Mount Sinai
How iPSCs Are Used in Medicine Today
The first medical breakthrough using iPSCs happened in September 2014. A team led by Masayo Takahashi at the RIKEN Center for Developmental Biology treated a 70-year-old woman with wet age-related macular degeneration. They reprogrammed her skin cells into iPSCs, then differentiated them into a small sheet of retinal pigment epithelial cells. After implantation into her eye, the procedure stopped the disease’s progression, improved her vision, and avoided the need for immunosuppressant drugs.
Today, iPSCs are reshaping medicine in several ways:
- Disease modeling: Scientists can grow patient-specific diseased cells - like neurons from someone with Alzheimer's - to study how diseases develop at a molecular level.
- Drug discovery: iPSCs provide human cell models that help researchers test drugs for safety and effectiveness more accurately.
- Personalized regenerative medicine: iPSCs are paving the way for individualized treatments, where therapies are tailored to the patient’s unique biology.
"Induced pluripotent stem cells have given us a window into human development unlike anything we had before. ... It's a game-changer for discovery about early human development."
– Arnold Kriegstein, MD, PhD, Director of UCSF's Eli and Edythe Broad Center of Regeneration Medicine and Stem Cell Research
Banking cord blood today could play a critical role in tomorrow’s iPSC therapies, serving as a form of biological insurance. As Yamanaka himself has pointed out, breakthroughs in treatment often require decades of research. By preserving cord blood, families can prepare for a future where iPSC technology might unlock even greater possibilities.
How Americord Connects Cord Blood Banking to Future iPSC Technology
Storing your baby's stem cells now could open doors to groundbreaking medical treatments in the future. Americord's preservation services create a link between today's FDA-approved therapies and tomorrow's advancements in iPSC (induced pluripotent stem cell) regenerative medicine.
The advantage lies in the quality of neonatal cells. Stem cells from cord blood and tissue have far fewer mutations compared to those from adults. Dr. Boris Greber, Head of R&D for iPSC at Catalent Cell & Gene Therapy, highlights this:
"We have shown that these neonatal starting cells indeed have a lower mutation load as compared to adult ones and that this translates into the iPSCs, resulting in a reduced mutational burden."
This lower mutation load makes neonatal stem cells a prime candidate for future iPSC reprogramming. Americord's storage plans are designed to preserve this cellular integrity, ensuring families are ready for potential iPSC-based therapies.
Americord's Stem Cell Banking Plans
Americord provides AABB-accredited, FDA-registered stem cell banking services with flexible family plans tailored to different medical needs. Their CryoMaxx™ Processing ensures maximum cell recovery and preserves tissue quality for future use.
| Plan Name | Services Included | Best For |
|---|---|---|
| Essential Family Plan | Cord Blood Banking | Families focused on FDA-approved blood/immune treatments |
| Advanced Family Plan | Cord Blood + Cord Tissue | Families exploring MSCs for regenerative medicine |
| Complete Family Plan | Cord Blood + Cord Tissue + Placental Tissue + Exosomes | Families seeking comprehensive coverage and readiness |
Americord's 5-compartment storage system allows for partial use of samples, preserving the rest for future therapies. For instance, in February 2024, a treatment for motor neuron disease used only a small portion of stored cells, leaving the majority intact for future needs.
On top of their advanced services, Americord offers transparent pricing to help families plan long-term. Processing fees range from $1,500 to $3,000, with annual storage costs between $175 and $250. Lifetime plans can save families up to 69%. Plus, Americord backs its services with a $110,000 quality guarantee.
Preparing Your Family for Future Medical Advances
Preserving stem cells provides a safety net for your family's future health. These cells are a perfect genetic match for your child and increase compatibility chances for siblings. Statistics show the likelihood of needing a stem cell transplant by age 70 is about 1 in 217, and experts estimate that 1 in 3 people could benefit from regenerative medicine over their lifetime.
Americord simplifies the process with its 4-in-1 collection kit, which gathers cord blood, cord tissue, placental tissue, and exosomes in one step during delivery. The American College of Obstetricians and Gynecologists (ACOG) suggests obtaining a collection kit at least six weeks before your due date. Many families use FSAs or HSAs to offset costs, often requiring a Letter of Medical Necessity.
By combining advanced collection techniques with the potential of iPSC technology, Americord ensures your stored stem cells remain ready for tomorrow's treatments. As Martin Smithmyer, CEO and Founder of Americord, puts it:
"With the confidence of the technologies and processes we are providing to families who want to store stem cells from their newborn... we are excited to offer the highest quality guarantee in the industry."
Conclusion
The progress from cord blood banking in the 1990s to today's iPSC advancements has transformed treatment possibilities. What began as a solution for leukemia and blood disorders has grown into a wide-ranging regenerative approach - spanning tissue repair to cutting-edge treatments for neurodegenerative conditions.
Americord has kept pace with these scientific developments, expanding its services beyond cord blood preservation to include cord tissue, placental tissue, and exosome banking. Their state-of-the-art laboratory in Somerset, New Jersey, is equipped to support the future of iPSC-based therapies, ensuring that the unique benefits of newborn cells are preserved for potential treatments down the line.
Newborn stem cells are particularly valuable due to their minimal mutations and long-lasting potency. As mentioned earlier, the unmatched quality of neonatal cells forms the foundation for emerging iPSC technologies. With lifetime storage plans extending up to 78 years, these preserved cells will be available when they're most likely to be needed - during adulthood, when degenerative diseases often arise.
By banking your baby's stem cells, you’re not only securing access to today's FDA-approved therapies but also positioning your family to benefit from future advancements in regenerative medicine. Marty Smithmyer, CEO and Founder of Americord, underscores this commitment:
"Through continuous innovation and learning, we are able to educate families and healthcare providers, ensuring the best long-term health outcomes, advice, and options."
Whether you choose the Essential Family Plan for cord blood banking or the Maximum Family Plan for a more comprehensive preservation package, you’re building a biological safety net. Banking stem cells today bridges the gap between current medical treatments and the exciting potential of personalized medicine.
FAQs
What’s the difference between cord blood, cord tissue, and placental stem cells?
The distinction comes down to their origins and the stem cells they offer. Cord blood is a source of hematopoietic stem cells (HSCs), which are mainly used in treatments for blood-related disorders. On the other hand, cord tissue and placental stem cells are abundant in mesenchymal stem cells (MSCs), which are being explored for their potential in regenerative medicine. While both have promising uses, cord blood is already FDA-approved for treating more than 80 conditions.
How likely is my family to actually use banked stem cells?
The chances of using banked stem cells depend on a mix of current medical needs and progress in regenerative medicine. While immediate use is uncommon, stored stem cells offer promising possibilities for future treatments, especially for conditions like blood disorders and immune system issues. Banking stem cells can offer reassurance and serve as a vital resource if a treatable condition emerges as research continues to broaden their potential uses.
Can banked newborn cells be used later to make iPSCs?
Banked newborn cells have the potential to be transformed into induced pluripotent stem cells (iPSCs) in the future. iPSCs are highly promising in the field of regenerative medicine and personalized treatments, opening up new opportunities to improve healthcare outcomes.
The views, statements, and pricing expressed are deemed reliable as of the published date. Articles may not reflect current pricing, offerings, or recent innovations.